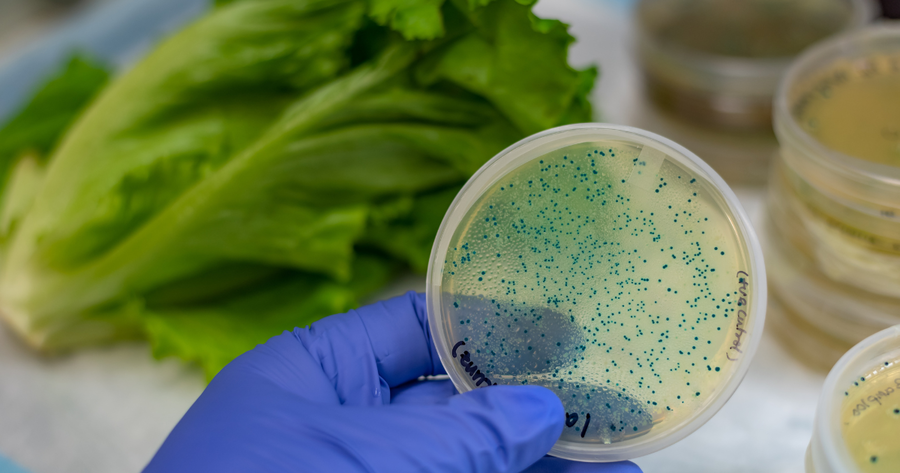

พรีไบโอติก ช่วยอะไร จุลินทรีย์ที่ดูแลลำไส้ซึ่งการดูแลลำไส้ พรีไบโอติก (Prebiotic) ที่กำลังเป็นเทรนด์สุขภาพ และได้รับความสนใจมากขึ้นเรื่อย ๆ เนื่องจากพรีไบโอติกสามารถปรับสมดุลแบคทีเรียดีในลำไส้ ทำให้ระบบย่อยอาหารทำงานได้ดี และส่งผลต่อสุขภาพโดยรวมของร่างกาย เพื่อให้เราเข้าใจมากขึ้น บทความนี้จะพาทุกคนไปทำความรู้จักประโยชน์ของพรีไบโอติก วิธีการทำงานในลำไส้ รวมทั้งแนะนำอาหารและผลิตภัณฑ์ที่มีพรีไบโอติกสูงให้ทุกคนดูแลลำไส้และสุขภาพได้ง่าย ๆ ทุกวัน

พรีไบโอติกคืออะไร
พรีไบโอติก (Prebiotic) คือ สารอาหารประเภทใยอาหารที่ร่างกายมนุษย์ไม่สามารถย่อยได้เอง แต่เป็นอาหารสำคัญของแบคทีเรียดีในลำไส้ อย่างเช่น Lactobacillus และ Bifidobacterium ซึ่งทำให้แบคทีเรียเหล่านี้เจริญเติบโตได้ดี และไปลดการทำงานของแบคทีเรียไม่ดี ช่วยปรับสมดุล gut microbiome ซึ่งสาร Prebiotic มีหลายประเภท ได้แก่ อินูลิน ฟรุกโตโอลิโกแซ็กคาไรด์ (FOS) และกาแลกโตโอลิโกแซ็กคาไรด์ (GOS) โดยแต่ละชนิดจะช่วยกระตุ้นแบคทีเรียดีแตกต่างกันไป และยังสามารถลดอาการท้องอืด ท้องเสีย และเพิ่มประสิทธิภาพการดูดซึมสารอาหาร สำหรับคนที่ไม่ค่อยกินผัก ผลไม้ หรือธัญพืช สามารถเลือกทานอาหารทางเลือกอื่น ๆ ที่มีพรีไบโอติกได้ เช่น โยเกิร์ตหรือนมเปรี้ยวพร้อมดื่มของ Butterfly Organic ที่มีทั้งพรีไบโอติกและโพรไบโอติกคับแน่นเต็มถ้วย ช่วยปรับสมดุลลำไส้ได้ง่าย ๆ

พรีไบโอติกช่วยเรื่องอะไรกับเราบ้าง
หลายคนสงสัยว่า ในเมื่อร่างกายเราย่อยพรีไบโอติก และพรีไบโอติกช่วยอะไร ซึ่งจริง ๆ แล้วมันมีประโยชน์หลายด้าน โดยเฉพาะต่อระบบย่อยอาหารและการทำงานของลำไส้ ไม่ว่าจะเป็น
- ปรับสมดุลจุลินทรีย์ในลำไส้ เพราะพรีไบโอติกช่วยให้แบคทีเรียดีเติบโต จึงทำให้ลำไส้สมดุล ลดอาการท้องผูก ท้องเสีย และแก๊สในลำไส้
- เพิ่มการดูดซึมสารอาหาร เพราะเมื่อแบคทีเรียดีทำงานเต็มที่ ร่างกายก็จะยิ่งดูดซึมแร่ธาตุและวิตามินที่จำเป็นได้เต็มที่
- ลดการอักเสบในลำไส้ จากกรดไขมันสายสั้น (SCFA) ที่ผลิตมาจากแบคทีเรียดี มีคุณสมบัติช่วยลดการอักเสบได้ และทำให้ลำไส้แข็งแรง
- ส่งผลดีต่อระบบภูมิคุ้มกัน หาก gut microbiome สมดุล จะช่วยให้ร่างกายต่อสู้กับเชื้อโรคได้ดีขึ้น

ประโยชน์ของพรีไบโอติกต่อร่างกาย
พรีไบโอติก มีประโยชน์ต่อร่างกายหลายด้าน และครอบคลุมทั้งระบบย่อยอาหาร ระบบภูมิคุ้มกัน และสุขภาพโดยรวม เมื่อเราทานพรีไบโอติก แบคทีเรียดีในลำไส้ก็จะมีมากขึ้น ทำให้ลดการเจริญเติบโตของแบคทีเรียก่อโรค และระบบขับถ่ายทำงานได้ราบรื่น ลดอาการท้องผูกและท้องอืด และโอกาสเกิดโรคต่าง ๆ ในลำไส้ เช่น ลำไส้แปรปรวนและโรคลำไส้ขี้เกียจ นอกจากนี้ยังช่วยเพิ่มการดูดซึมวิตามินและแร่ธาตุสำคัญ เช่น แคลเซียม แมกนีเซียม และวิตามินบี ซึ่งดีต่อการทำงานของร่างกาย รวมทั้งสาร SCFA ที่ผลิตโดยแบคทีเรียดี ยังช่วยควบคุมระดับน้ำตาลและไขมันในเลือด ส่งผลดีต่อหัวใจ และที่ดีมาก ๆ เลยก็คือ ช่วยปรับสมดุลจิตใจ ลดความเสี่ยงต่อภาวะซึมเศร้า เนื่องจากระบบที่ลำไส้ที่ดีส่งผลโดยตรงกับการทำงานของสมองได้ ทำให้สุขภาพกายและใจดีขึ้นพร้อมกัน

พรีไบโอติกทำงานอย่างไรในลำไส้
หลักการทำงานของพรีไบโอติก คือ การเป็นอาหารของแบคทีเรียดี เมื่อเราได้รับ Prebiotic เช่น อินูลินหรือ ฟรุกโตโอลิโกแซ็กคาไรด์ (FOS) แบคทีเรียจะใช้เป็นสารอาหารในการเจริญเติบโตและขยายจำนวน ทำให้ gut microbiome ในลำไส้สมดุล โดยแบคทีเรียดีจะผลิตกรดไขมันสายสั้น (SCFA) เช่น Butyrate, Acetate, Propionate ซึ่งช่วยลดความเป็นกรดในลำไส้ ควบคุมจำนวนของแบคทีเรียไม่ดีไม่ให้มากเกินไป ลดการอักเสบในลำไส้ ช่วยให้ระบบภูมิคุ้มกันทำงานดี และกระตุ้นการทำงานของลำไส้ ทำให้ระบบขับถ่ายดีขึ้น ลดอาการลำไส้ขี้เกียจ ร่างกายจึงดูดซึมสารอาหารได้เต็มที่
พรีไบโอติกกับโพรไบโอติก ต่างกันอย่างไร
หลายคนมักสับสนระหว่างพรีไบโอติก และโพรไบโอติก ความแตกต่างระหว่างสองคำนี้คือ โพรไบโอติก หมายถึงแบคทีเรียดีที่ช่วยสร้างสมดุลลำไส้โดยตรง ส่วนพรีไบโอติก คืออาหารของโพรไบโอติก ที่ช่วยให้แบคทีเรียดีเติบโตและทำงานได้เต็มประสิทธิภาพ ง่าย ๆ คือ พรีไบโอติกเหมือนอาหารเช้าให้แบคทีเรียดีมีพลังทำงานเต็มที่ การกินโพรไบโอติกพร้อมพรีไบโอติกจะช่วย ปรับสมดุลของโพรไบโอติกได้ดี
พรีไบโอติก vs โยเกิร์ต
โยเกิร์ตถือเป็นแหล่งของโพรไบโอติกที่ช่วยเสริมสมดุลจุลินทรีย์ในลำไส้ได้เป็นอย่างดี แต่หากอยากให้ประสิทธิภาพเพิ่มขึ้นมากกว่าเดิม การรับประทานคู่กับพรีไบโอติกก็เป็นทางเลือกที่น่าสนใจ เพราะพรีไบโอติกเป็นใยอาหารที่ร่างกายไม่สามารถย่อยได้ แต่จุลินทรีย์ดีในลำไส้นำไปใช้เป็นแหล่งอาหารได้โดยตรง โยเกิร์ตบางชนิด เช่น โพร พลัส โยเกิร์ตพร้อมดื่มจาก Buterfly Organic ที่มีทั้งพรีไบโอติกและโพรไบโอติกในถ้วยเดียว กลายเป็นอาหารในกลุ่มซินไบโอติก ที่ส่งผลดีต่อสุขภาพลำไส้มากขึ้น แต่พรีไบโอติกต้องกินในปริมาณที่เหมาะสม เพราะหากมากเกินไปอาจทำให้เกิดแก๊สและอาการท้องอืดได้

อาหารที่มีพรีไบโอติกสูง
ในอาหารทั่วไปที่มีพรีไบโอติกสูงที่เราอาหารทานได้ ได้แก่ หัวหอม กระเทียม หน่อไม้ฝรั่ง ข้าวโอ๊ต และกล้วยสุก นอกจากนี้ ผลิตภัณฑ์ Butterfly Organic ที่มีทั้งพรีไบโอติกและโพรไบโอติก ถือเป็นอาหารที่สามารถทานได้ง่าย และช่วยเพิ่มจุลินทรีย์ดีในลำไส้ได้จริง เหมาะสำหรับไลฟ์สไตล์คนเมือง หรือคนที่มองหาอาหารเพื่อสุขภาพ การทานอาหารเหล่านี้สม่ำเสมอร่วมกับโพรไบโอติกช่วยให้ระบบย่อยอาหารและลำไส้ทำงานเต็มที่
ผักผลไม้ที่มีพรีไบโอติก
ผักและผลไม้หลายชนิดที่มีใยอาหารและพรีไบโอติกธรรมชาติ ได้แก่ หน่อไม้ฝรั่ง กระเทียม หัวหอม หน่อไม้ บร็อกโคลี และกล้วยสุก ซึ่งพรีไบโอติกจากธรรมชาติเหล่านี้ช่วยให้แบคทีเรียดีเติบโต ปรับสมดุล gut microbiome และลดอาการท้องผูกหรือท้องอืดได้
พรีไบโอติก ธรรมชาติ มีอะไรบ้าง
พรีไบโอติกจากธรรมชาติมักพบในอาหารที่มีใยอาหารสูง เช่น พบอินูลินได้ในหัวหอม กระเทียม และธัญพืชเต็มเมล็ด การเลือกทานพรีไบโอติกจากธรรมชาติช่วยให้ร่างกายได้รับสารอาหารครบถ้วน และปรับสมดุล gut microbiome อย่างเป็นธรรมชาติได้อีกทาง

พรีไบโอติก กินตอนไหนดีที่สุด
เวลาที่ดีที่สุดสำหรับการกินพรีไบโอติก คือ ช่วงเช้าหรือก่อนอาหาร เพื่อให้แบคทีเรียดีในลำไส้ได้รับอาหารจนมีพลังงานเพียงพอ จนสามารถช่วยกระตุ้นการทำงานของลำไส้ได้ เรียกได้ว่ากระตุ้นการสมดุลตั้งแต่เช้า
เนื่องจากพรีไบโอติกเป็นสารอาหารสำคัญที่ช่วยปรับสมดุล gut microbiome ทำให้ระบบย่อยอาหารและลำไส้ทำงานปกติ ลดอาการท้องอืด ท้องเสีย และช่วยให้ร่างกายดูดซึมสารอาหารเต็มที่ จนมีลำไส้แข็งแรงและมีสุขภาพดีในระยะยาว โดยสามารถกินอาหารธรรมชาติที่มีพรีไบโอติกสูง เช่น หัวหอม กระเทียม หน่อไม้ฝรั่ง ข้าวโอ๊ต และกล้วยสุก หรือจะเป็นอาหารอื่น ๆ เช่น โยเกิร์ต หรือนมเปรี้ยว ก็เหมาะจะกินในตอนเช้าร่วมกับมื้ออาหารหลักได้เช่นกัน
พรีไบโอติกเป็นสิ่งที่จำเป็นต่อร่างกายได้มากกว่าที่คิด โดยเฉพาะระบบลำไส้ ย่อยอาหาร และระบบขับถ่าย ทำให้หลายคนหันมาสนใจดูแลสุขภาพด้วยอาหารที่มีพรีไบโอติกกันมากขึ้น ซึ่งปัจจุบันก็มีในรูปแบบที่หาทานได้ง่าย ทั้งแบบอาหารเสริม ในธรรมชาติ รวมทั้งมาในรูปแบบโยเกิร์ตและนมเปรี้ยวพร้อมดื่ม ที่เหมาะสำหรับคนทุกวัย โดยเฉพาะคนที่รักษาสุขภาพและรูปร่างเป็นอย่างดี ซึ่งมีผลดีต่อการเจริญเติบโตของโพรไบโอติกในร่างกาย ทำให้สุขภาพลำไส้ยั่งยืนในระยะยาวได้อีกด้วย
คำถามที่พบบ่อย เกี่ยวกับพรีไบโอติก
ช่วงเวลาที่เหมาะสมสำหรับการกินพรีไบโอติก คือก่อนมื้ออาหารหรือพร้อมมื้ออาหารเช้า เพื่อให้จุลินทรีย์ดีในลำไส้ใช้เป็นอาหารได้เต็มที่และช่วยปรับสมดุลลำไส้ได้อย่างมีประสิทธิภาพตั้งแต่เริ่มวัน
โพรไบโอติกที่เหมาะสำหรับผู้หญิง ได้แก่ โยเกิร์ต กรีกโยเกิร์ต นมเปรี้ยว และโยเกิร์ตพร้อมดื่ม จาก Butterfly Organic ซึ่งมีจุลินทรีย์ดีหลายสายพันธุ์พร้อมพรีไบโอติก ช่วยปรับสมดุลลำไส้และช่องคลอด ลดอาการท้องอืด ท้องเสีย และเสริมภูมิคุ้มกัน เหมาะกับผู้หญิงทุกวัย
โพรไบโอติกไม่เหมาะสำหรับผู้ที่มีภาวะภูมิคุ้มกันต่ำรุนแรง หรือผู้ที่ได้รับการปลูกถ่ายอวัยวะบางราย โดยควรปรึกษาแพทย์ก่อนใช้เพื่อความปลอดภั
พรีไบโอติกควรกินอย่างต่อเนื่อง และผสมผสานกับอาหารที่มีใยอาหารสูง เช่น ผัก ผลไม้ และธัญพืช เพื่อช่วยให้โพรไบโอติกเจริญเติบโตและปรับสมดุลลำไส้ได้เต็มประสิทธิภาพ
พรีไบโอติกมีหลายชนิด เช่น อินูลิน (Inulin) ฟรุกโตโอลิโกแซ็กคาไรด์ (FOS) กาแลคโตโอลิโกแซ็กคาไรด์ (GOS) และใยอาหารจากผัก ผลไม้ หรือธัญพืช ซึ่งทั้งหมดช่วยเป็นอาหารให้จุลินทรีย์ดีในลำไส้เจริญเติบโต